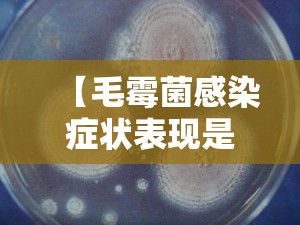

毛霉菌病症状
呼吸系统症状:咳嗽、咳痰、发热、呼吸困难和胸痛等,咳血较为常见。全身症状:高热、呼吸加快等。影像学表现:胸部X线检查显示渗出性实变影和软组织密度的肿块影,常有多发不规则空洞形成。CT检查可见晕轮征和气体新月征。诊断方法:组织活检:发现毛霉菌丝和以血栓形成及组织坏死为特征的病理改变。

鼻脑毛霉菌病通常表现为突发性且严重,可能导致死亡。病变在鼻粘膜和腭部尤为明显,菌丝侵入血管可引起鼻中隔、腭部和眼眶周围骨骼的持续组织坏死,症状包括剧烈疼痛、发热、眼眶周围炎症、眼球突出、脓性鼻涕以及粘膜坏死。
鼻脑毛霉病:急性起病,症状严重,包括面部疼痛、头痛、嗜睡,甚至可能导致失明。鼻腔内可见褐色、血性分泌物,感染侧腭部有黑色焦痂。脑神经受累时,会出现瞳孔异常、视力障碍。疾病进展可能导致脑血管梗死和坏死,患者可迅速昏迷,病死率高达80%~90%。
毛霉菌感染比癌症难治吗
霉菌感染首先要确定是什么类型的霉菌感染,其中毛霉菌感染是较为严重的一种。如果毛霉菌感染严重,可能会影响人的寿命。因此,最好在毛霉菌感染早期就进行治疗。接下来,我们将具体介绍毛霉菌感染的相关知识。 毛霉菌感染的临床表现包括伤口处的棉絮状真菌病变,迅速侵入深层组织。
毛霉菌感染的致死率达到了50%,对于一些患有艾滋病、癌症等人群来说,致死率达到了80%。可见这种疾病其实并不可怕,只要我们能够经常锻炼身体,有一个好的免疫力,平时讲究卫生就没有必要过于担心。
反晕征和低密度征:是典型的肺毛霉菌病表现,但较为少见。非癌症人群中的表现:侵袭性肺曲霉菌病和毛霉菌病在非癌症人群中与“非典型”非结节性表现相关,包括实变和磨玻璃影。
身体一个或多个深层器官的真菌感染。体温升高和中性粒细胞减少患者中疑似真菌感染(中性粒细胞减少症可能是癌症治疗的副作用)。在给患者使用安必素之前,医生会检查患者的发烧不是由细菌或病毒引起的。内脏利什曼病,一种由寄生虫引起的疾病。用法用量:安必素总是由医生或护士进行注射,通过点滴方式注入静脉。
根据医学统计,在过去的30年间,我国的肺癌发病率增加了465%,它已经去取代了肝癌,成为了导致我们因为肿瘤死亡的首位原因。但是肿瘤的发生只是一种疾病,而造成了死亡的真正原因,更多的是因为肺部感染。
毛霉菌感染临床表现
1、呼吸系统症状:咳嗽、咳痰、发热、呼吸困难和胸痛等,咳血较为常见。全身症状:高热、呼吸加快等。影像学表现:胸部X线检查显示渗出性实变影和软组织密度的肿块影,常有多发不规则空洞形成。CT检查可见晕轮征和气体新月征。诊断方法:组织活检:发现毛霉菌丝和以血栓形成及组织坏死为特征的病理改变。
2、根据临床表现,毛霉菌病可以分为脑型、肺型和胃肠道型。脑型毛霉菌病是由于毛霉菌从鼻腔、副鼻窦沿小血管到达脑部,导致血栓和坏死;肺型主要表现为支气管肺炎,亦有肺梗塞及血栓形成;胃肠道型则常见于回肠末端、盲肠及结肠,食道及胃亦可受累。
3、毛霉菌感染发生在伤口处的棉絮状真菌病变开始,迅速侵入深层组织。毛霉菌可表现为六种临床类型。肺和鼻腔粘膜炎是最常见的临床表现。其他类型包括弥散型、胃肠型、皮肤型和肾脏型。胸痛、呼吸困难、咯血等症状,胸片及常规细菌学检查均不能确诊。两性霉素B是最好的全身治疗方法。
4、毛霉菌感染的临床表现包括伤口处的棉絮状真菌病变,迅速侵入深层组织。毛霉菌可表现为六种临床类型,肺和鼻腔粘膜炎最常见。其他类型包括弥漫型、胃肠型、皮肤型和肾脏型。患者可能出现胸痛、呼吸困难、咯血等症状,但胸片及常规细菌学检查不能确诊。两性霉素B是较好的全身治疗方法。
肺毛霉菌病症状体征
肺毛霉菌病的症状和体征多种多样,主要表现为: 鼻脑毛霉病:急性起病,症状严重,包括面部疼痛、头痛、嗜睡,甚至可能导致失明。鼻腔内可见褐色、血性分泌物,感染侧腭部有黑色焦痂。脑神经受累时,会出现瞳孔异常、视力障碍。疾病进展可能导致脑血管梗死和坏死,患者可迅速昏迷,病死率高达80%~90%。
肺部霉菌感染早期通常是以不同程度的咳嗽、咳痰、咯血、胸闷、气喘等呼吸道症状为主要临床表现,还包括有发热、畏寒、头疼、流涕、肌肉及关节酸痛等全身症状。肺部霉菌感染是指由真菌感染引起的肺部疾病,临床中比较常见的真菌病原体主要有念珠菌、曲霉菌、毛霉菌和隐球菌等。
诊断肺毛霉菌病主要通过综合分析临床表现、病理和实验室检查。在组织病理学检查中,肺毛霉病的特征并不明显,主要依赖于组织切片中的特征性发现,即观察到无或分隔稀少的粗大菌丝,它们能侵犯动脉管壁,导致梗死和邻近组织的坏死。
毛霉菌感染是怎么引起的
病原体:主要由毛霉菌目中的毛霉菌、根霉菌等引起。感染途径:经吸入孢子引起,健康人肺泡巨噬细胞可清除吸入的孢子,故本病多发生于具有严重基础疾病和诱发因素者。
毛霉菌病的病因主要由毛霉菌目中的根霉菌和毛霉菌感染引起。以下是关于毛霉菌病病因的详细解释:病原体:根霉菌:倾向于感染人体的鼻腔、鼻窦、大脑以及消化系统。毛霉菌:主要侵袭肺部。病原菌分布与传播:广泛分布:这些病原菌在自然界中广泛分布,尤其常见于粮食和水果。
毛霉菌病(mucormycosis)是由环境中自然存在的“毛霉”真菌引发,是一种罕见但可能导致严重后果的疾病。其特征为菌丝侵犯血管,引起血栓形成及坏死,产生鼻、脑、消化道及呼吸道等处病变,预后严重。
毛霉菌普遍存在于土壤、蔬菜、水果和空气中。可通过吸入真菌孢子引起鼻部、眼眶和脑部感染;吸入呼吸道可引起肺部毛霉菌病。皮肤黏膜有创伤时,可通过皮肤接触引起皮肤毛霉菌病;食入污染真菌孢子的食物可引起消化道疾病。
根霉菌肺部感染的治疗
神经系统症状:病情恶化时,坏死区域可能扩散至大脑,引发惊厥、言语障碍或肢体麻痹。肺部感染症状:肺部感染的症状与侵袭性曲菌病相似,可能包括咳嗽、呼吸困难、胸痛等。皮肤感染症状:在使用封闭敷料的情况下可能发生皮肤感染,特别是与根霉菌有关。皮肤感染症状可能包括红肿、疼痛、坏死等。
糖尿病酮酸中毒患者易受感染,而慢性肾病患者在接受肾去铁胺治疗、免疫抑制患者,特别是伴有中性粒细胞减少或大剂量皮质类固醇治疗的人群也容易成为机会性感染的靶点。肺部感染与侵袭性曲菌病相似,而皮肤感染在使用封闭敷料的情况下可能发生,特别是与根霉菌有关。
致病性接合菌以毛霉菌最多见,经血液或淋巴液播散可致肺部感染,其次为切口感染。致病性隐球菌多为新型隐球菌,主要侵犯脑,其次为肺。此外赛多孢霉菌、腐皮镰刀菌、根霉菌、球孢子菌、卡氏肺孢子虫等感染也有报道。术后早期真菌感染常见致病菌为念珠菌,中远期以曲霉菌感染为主,卡氏肺孢子虫及变形虫感染发生更晚。
对症治疗:患者可能会出现呼吸困难、咯血等症状,需要服用止咳药物,如止咳糖浆,以减轻症状。如果感染了其他类型的病原菌,可能需要注射广谱抗生素。 手术治疗:如果肺部出现化脓迹象,可能需要进行手术将脓肿切开,引流脓液,并继续使用抗真菌药物。
本文来自作者[admin]投稿,不代表东方磨具立场,如若转载,请注明出处:http://www.dongfangmoju.com/jiehuokepu/46.html








评论列表(4条)
我是东方磨具的签约作者"admin"!
希望本篇文章《【毛霉菌感染症状表现是什么,毛霉菌感染的治疗方法】》能对你有所帮助!
本站[东方磨具]内容主要涵盖: 毛霉菌感染症状表现是什么,
本文概览:成都9月14曰新增病例分布在那几个区1、高新区、锦江区等。根据查询相关资料显示:2022年9月14日成都市新增本土确诊病例8例,新增本土无症状感染者14例,分别分布于高新区、锦江区、青羊区和武侯区,疫情期间应积极主动参与并配合做好区域核酸...